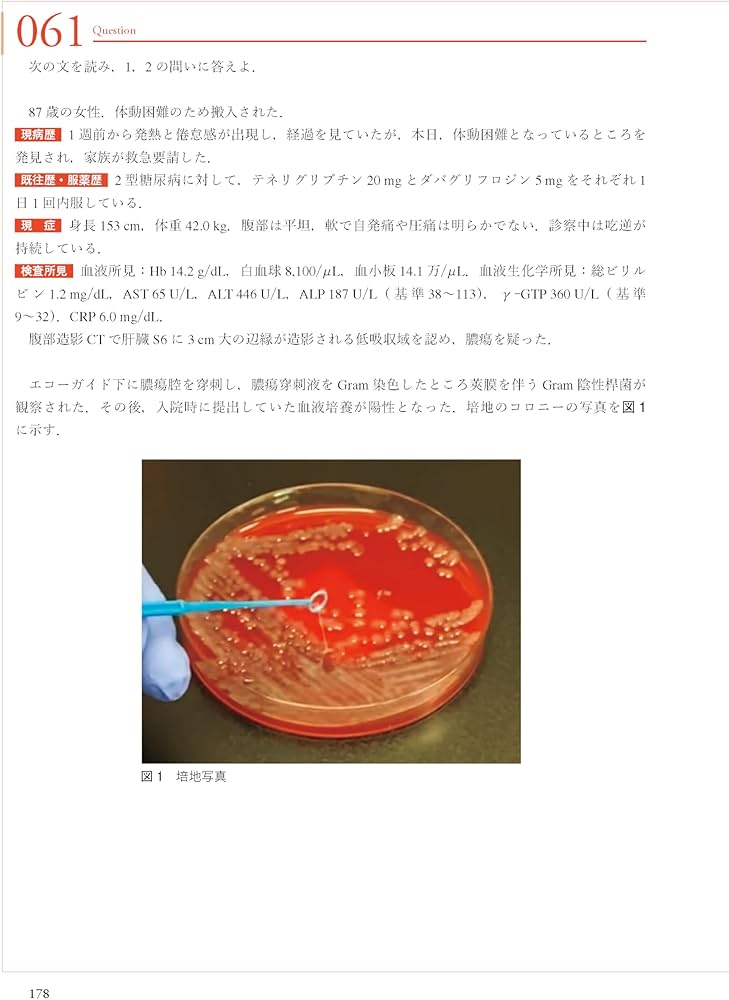
THE総合内科ドリルVer.2(1,2セット)WEB版使用済 THE総合内科ドリルVer

THE総合内科ドリル Ver.2 Amazon.co.jp: THE総合内科ドリル (Ver.2) 2 WEB版付: 呼吸器・血液
(2954件)
Pontaパス特典
サンキュー配送
7540円(税込)
76ポイント(1%)
Pontaパス会員ならさらに+1%ポイント還元!
送料
(
)
2942
配送情報
お届け予定日:2026.04.26 18:6までにお届け
※一部地域・離島につきましては、表示のお届け予定日期間内にお届けできない場合があります。
ロットナンバー
5738276232
お買い物の前にチェック!

Pontaパス会員なら
ポイント+1%
ポイント+1%
商品説明

ご覧いただきありがとうございます。2025年7月に出版されたTHE総合内科ドリルVer.2の2冊セットです。総合内科専門医試験対策に使用しました。勉強したため使用感はありますが、書き込みはなくWEB版のQRコードも未使用です。試験対策として有用でしたのでいかがでしょうか。即購入可。他にも内科専門医試験、総合内科専門医試験対策のテキストを出品しておりますのでよろしければご覧ください。#医師国家試験#内科専門医試験#総合内科専門医試験
| カテゴリー: | 本・雑誌・漫画>>>本>>>健康・医学 |
|---|---|
| 商品の状態: | 目立った傷や汚れなし","細かな使用感・傷・汚れはあるが、目立たない |
| 配送料の負担: | 送料込み(出品者負担) |
| 配送の方法: | 佐川急便/日本郵便 |
| 発送元の地域: | 福島県 |
| 発送までの日数: | 2~3日で発送 |
レビュー
商品の評価:




 4.7点(2954件)
4.7点(2954件)
- z gogg-e
- シリーズになっているみたいなので、出来れば全部購入したいと思いました
- ayaya1834
- 病院に行った日はお母さんに1冊ずつ買って貰ってました。 こんな子いるかな…大好きでした♪
- dreamerb2221
- 娘の3歳の誕生日に買いました。 絵が細かいところまでかかれていて見ていてワクワク楽しい気持ちになります。ただ読むだけじゃなくて、結婚パーティーの招待状を探したり、時計店の時計をページを遡って探したり、このお馬さんこっちのページにも居たよねー?と色んな楽しみ方ができます。 大人も見てて楽しい絵本です。うちでは毎晩寝る前の定番です。
- たけパパ2000
- 子供へのプレゼントに頼まれたので購入しました。もう5冊目くらいですが毎回楽しんでいます。 大人も夢中になれます。
- mitu12219541
- 友人の出産祝いに送りました。 まだ生後2ヶ月ですが目で追っているような気がするとのこと(о´∀`о)
- まあちやん2847
- 発送がとても早くて助かりました。梱包もとても丁寧でした。
- みわ1118
- 6ヶ月の娘への読み聞かせ用に購入しました。 1歳になるまでの間に、よく読んだ絵本のベスト3。 . 絵が鮮やかだからか、目が惹きつけられるようです。 オススメです。
- アン0505
- 読み聞かせ用に購入しました。 . 1歳5ヶ月になった今でも、読んで欲しいと娘が私に渡して来る絵本の1冊です。 「ガタンゴトン ガタンゴトン」の繰り返しが面白いのかな。 . 私は、登場人物のつぶらな手口が好きですね。 絵が可愛いです。
- moko19840730
- 読み聞かせ用に購入しました。 「だるまさん『が』」を義母に買ってもらったばかりですが、娘が気に入ったようだったので。 . だるまさんが...ころんだ!とはいかない、面白さ。 「だるまさん『の』」も意外な展開で、 思わずクスッと笑えます。 小さい月齢から楽しめると思います。オススメです。
すべて見る
お店の情報
7,367
連絡・応対
4.3
配送スピード
4.3
梱包
4.3

![THE総合内科ドリル [WEB版付] | 書籍詳細 | 書籍 | 医学書院](/jcfxu/nHR0pHM6Yy93q3cuaWqhn3Utc2uvaW4uY28uanNvYXOw/oGljYXRpo24vZmlsZXMvMjIxNi8xATV2LzQyMDAvMTN4ZzI0LmpwZw--.jpg)
![THE内科専門医問題集(Ver.2)1 [WEB版付] | 書籍詳細 | 書籍 | 医学書院](/jcfxu/nHR0pHM6Yy93q3cuaWqhn3Utc2uvaW4uY28uanNvYXOw/oGljYXRpo24vZmlsZXMvNjIxNy8wBDHwLzEyMzUvMTRxATYwLmpwZw--.jpg)

































